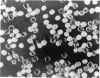
36

Abstract
During fine structure analyses of artificially induced waxy mutants in maize by use of Nelson's pollen analysis methods, it was noticed that some mutants showed a phenotype intermediate between waxy and normal nonwaxy. Such intermediate or leaky waxy mutants were frequent among mutants induced by a chemical mutagen, EMS. They seemed to be located evenly within the waxy locus. This would suggest that they might have been missense mutations, which would produce full-sized but partially inactivated enzymes, rather than deletions or frameshift mutations. To confirm the intermediate phenotype, a rapid measuring system was developed to measure waxiness of endosperm quantitatively. It was based on the blue value method and is applicable to a single grain of rice. Among the 27 waxy mutant lines of maize, including 11 EMS-induced, two of the EMS-induced mutants were clearly intermediate. Eighteen EMS induced wx mutants of rice were also examined, and nine were intermediate.
Full text
PDF






Images in this article
Selected References
These references are in PubMed. This may not be the complete list of references from this article.
- Amano E. Comparison of ethyl methanesulfonate- and radiation-induced waxy mutants in maize. Mutat Res. 1968 Jan-Feb;5(1):41–46. doi: 10.1016/0027-5107(68)90079-1. [DOI] [PubMed] [Google Scholar]
- Amano E., Smith H. H. Mutations induced by ethyl methanesulfonate in maize. Mutat Res. 1965 Aug;2(4):344–351. doi: 10.1016/0027-5107(65)90070-9. [DOI] [PubMed] [Google Scholar]
- Brookes P., Lawley P. D. The reaction of mono- and di-functional alkylating agents with nucleic acids. Biochem J. 1961 Sep;80(3):496–503. doi: 10.1042/bj0800496. [DOI] [PMC free article] [PubMed] [Google Scholar]
- Chourey P. S., Schwartz D. Ethyl methanesulfonate-induced mutations of the Sh1 protein in maize. Mutat Res. 1971 Jun;12(2):151–157. doi: 10.1016/0027-5107(71)90136-9. [DOI] [PubMed] [Google Scholar]
- Creech R G. Genetic Control of Carbohydrate Synthesis in Maize Endosperm. Genetics. 1965 Dec;52(6):1175–1186. doi: 10.1093/genetics/52.6.1175. [DOI] [PMC free article] [PubMed] [Google Scholar]
- Kleinhofs A., Owais W. M., Nilan R. A. Azide. Mutat Res. 1978;55(3-4):165–195. doi: 10.1016/0165-1110(78)90003-9. [DOI] [PubMed] [Google Scholar]
- Loveless A. Possible relevance of O-6 alkylation of deoxyguanosine to the mutagenicity and carcinogenicity of nitrosamines and nitrosamides. Nature. 1969 Jul 12;223(5202):206–207. doi: 10.1038/223206a0. [DOI] [PubMed] [Google Scholar]
- Moore C. W., Creech R. G. Genetic Fine Structure Analysis of the AMYLOSE-EXTENDER Locus in ZEA MAYS L. Genetics. 1972 Apr;70(4):611–619. doi: 10.1093/genetics/70.4.611. [DOI] [PMC free article] [PubMed] [Google Scholar]
- Moore C. W., Creech R. G. Genetic Fine Structure Analysis of the AMYLOSE-EXTENDER Locus in ZEA MAYS L. Genetics. 1972 Apr;70(4):611–619. doi: 10.1093/genetics/70.4.611. [DOI] [PMC free article] [PubMed] [Google Scholar]
- Nelson O E. The Waxy Locus in Maize. I. Intralocus Recombination Frequency Estimates by Pollen and by Conventional Analyses. Genetics. 1962 Jun;47(6):737–742. doi: 10.1093/genetics/47.6.737. [DOI] [PMC free article] [PubMed] [Google Scholar]
- Nelson O. E. The Waxy Locus in Maize III. Effect of Structural Heterozygosity on Intragenic Recombination and Flanking Marker Assortment. Genetics. 1975 Jan;79(1):31–44. doi: 10.1093/genetics/79.1.31. [DOI] [PMC free article] [PubMed] [Google Scholar]
- Stadler L. J., Roman H. The Effect of X-Rays upon Mutation of the Gene A in Maize. Genetics. 1948 May;33(3):273–303. doi: 10.1093/genetics/33.3.273. [DOI] [PMC free article] [PubMed] [Google Scholar]